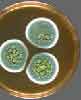
Αποκωδικοποιήθηκε το γονιδίωμα της πενικιλλίνης

Αποκωδικοποιήθηκε το γονιδίωμα του οικόσιτου χοίρου
Σικάγο: Διεθνής ερευνητική κοινοπραξία προσδιόρισε την πλήρη γενετική αλληλουχία του οικόσιτου χοίρου, ένα επίτευγμα που αναμένεται να βελτιώσει την στην κτηνοτροφία, να βοηθήσει στην καταπολέμηση ανθρώπινων ασθενειών και να προσφέρει νέα στοιχεία για τη διαδικασία της εξέλιξης

Αριθμός Πιστοποίησης Μ.Η.Τ.232442
Αριθμός Πιστοποίησης Μ.Η.Τ.232442